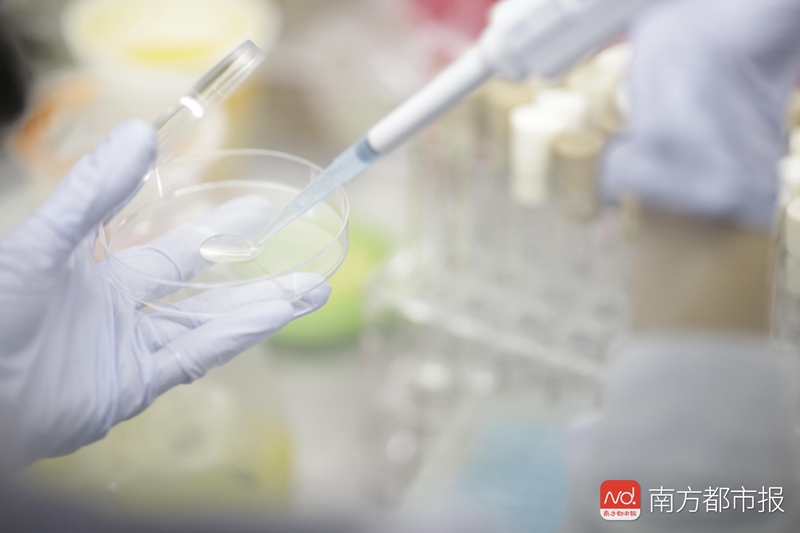
1551496051303033.jpg 4.jpg
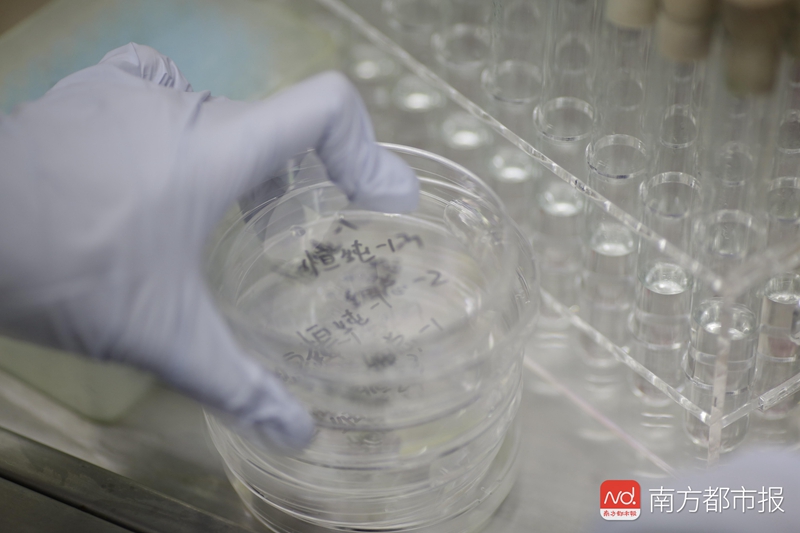
1551496078866548.jpg 5.jpg

“天使之橙”吃了百万罚单后,在商超等公共场所常见的智能榨汁机,出品的现榨橙汁卫生情况受到广泛关注。
2月22日,南都鉴定随机选取广州市场常见的两品牌智能榨汁机的现榨橙汁样品进行微生物检测。结果显示,本次选取样品的“橙汁先生”和“恒纯”两个品牌现榨果汁的菌落总数、霉菌和酵母计数、大肠菌群均不合格,最高超标3万多倍。专家表示,如果消费者食用微生物超标严重的食品,可能引起肠道疾病,出现呕吐、腹泻等症状,危害人体健康安全。

鉴定由头
“天使之橙”智能榨汁机
因为食品安全吃百万罚单
逛街累了,只需要按一下摁扭,然后通过手机支付,就可以喝到一杯鲜榨橙汁。得益于人工智能、移动支付、物联网等技术的快速发展,市场上涌现出一批无人新零售产品。智能现榨橙汁机,就是这种移动智能时代的消费产品。这些新零售的出现一定程度上满足了当前消费者个性化、多元化、便利化等消费需求。但此前,“天使之橙”品牌现榨橙汁自动贩售机,因为食品安全吃“百万罚单”,深陷舆论漩涡。智能榨汁机里的橙子质量有保证吗?会不会有发霉的橙子?榨出的橙汁健康卫生吗?

鉴定实录
我的橙汁卫生安全吗?
时间:2月22日~3月1日
地点:广州市微生物研究所
测试项目:菌落总数、大肠菌群计数、金黄色葡萄球菌检验、沙门氏菌检验、霉菌和酵母计数。
样品:在广州某商城对“橙汁先生”、“恒纯”两个品牌的智能榨汁机进行随机取样,数量为每个品牌5杯
标准:《GB4789.1-2016 食品安全国家标准 食品微生物检验 总则》、《GB/T4789.21-2003 食品安全国家标准 食品卫生微生物学检验 冷冻饮品、饮料检验》、《GB7101-2015 食品安全国家标准 饮料》、《GB29921-2013 食品安全国家标准 食品中致病菌限量》
(注:检测结果仅对样品负责)
【菌落总数】
两品牌橙汁均超标
超出最高安全限量值15倍,或致肠道疾病
据悉,菌落总数是用以判定食品被细菌污染的程度,反映食品的新鲜程度和卫生状况的重要微生物指标之一。如果食品的菌落总数严重超标,说明其产品的卫生状况达不到基本的卫生要求,将会破坏食品的营养成分,加速食品的腐败变质,使食品失去食用价值。

工程师进行样本前处理
消费者食用微生物超标严重的食品,有什么危害?广州市微生物研究所黄耀雄工程师表示,这可能会引起肠道疾病,甚至出现呕吐、腹泻等症状,危害人体健康安全。“原料、加工场所、包装等食品加工环节受到污染是直接导致菌落总数不合格的主要原因”。
2月22日现场取样时,在“橙汁先生”智能橙汁机上,记者发现粘贴有营业执照、食品经营许可证和机器清洗维护点检表。清洗维护表格显示,在12月1日~12日,都有人来更换橙汁桶、清理橙皮和清洁机器内外卫生,但之后日期的表格显示为空白。
检测结果显示,本次选取样品的两个品牌,菌落总数项目均不合格。其中,“橙汁先生”5杯样品的菌落总数检出值,均超过微生物指标的最高安全限量值10的四次方CFU/mL, 甚至超出最高安全限值15倍。“恒纯”也有三杯超标,最高超标5.5倍。
【霉菌和酵母菌】
“橙汁先生”超标3万多倍
加工原料可能腐败变质
工程师介绍,霉菌和酵母对食品的污染在食品微生物污染中占有很大比重。如果食品中霉菌和酵母超标,可能会改变食品的色、香、味,而其中部分霉菌的代谢产物也具有一定的毒性。如黄曲霉毒素、青霉毒素等。食用霉菌和酵母超标的食品,会危害人体健康安全。霉菌和酵母超标的主要原因,可能是加工用原料受污染,或者产品压榨、加工程序控制不当导致流通环节抽取的样品被污染。
样本前处理后放置培养皿
《GB7101-2015 食品安全国家标准 饮料》中规定,饮料中霉菌和酵母不得超过20CFU/mL。检测结果显示, “橙汁先生”样品霉菌酵母菌计数最高达6.9×10的5次方CFU/mL,超标3万多倍;“恒纯”样品霉菌酵母菌计数最高一杯7.6×10的4次方CFU/mL,超标3000多倍。
【大肠菌群】
“橙汁先生”超出最高安全限量值370倍
可能引起肠道传染病或食物中毒
据悉,大肠菌群是国内外通用的食品污染常用指示菌之一。大肠菌群值越大表示食品受大肠菌群污染越严重,产品卫生质量越差。如果消费者食用大肠菌群严重超标的食品,可能会引起肠道传染病或食物中毒,引起呕吐、腹泻等症状,危害人体健康安全。
处理好的培养皿放进恒温箱进行测试
本次检出两品牌橙汁样品的大肠菌群均不符合标准要求。“橙汁先生”的五个样品均超标,甚至超出最高安全限量值370倍,“恒纯”有3个样本检验结果超标,最高超标129倍。
鉴定补充
品牌方回应
每天都有消毒清洁
记者拨通“恒纯”官网热线,客服向南都记者表示,该公司有严格的卫生消毒步骤,也有资质报告。据悉,“恒纯”为河南恒纯农业科技有限公司旗下品牌,官网宣称“橙子从果树上采摘下来以后,就进入了冷库,用冷链配送到自动贩卖机,贩卖机也是冷藏机”,并且“与橙汁接触的所有材料均满足国家食品安全标准”。
“橙汁先生”的官网显示,该品牌在机场、高铁、地铁等大型客运枢纽市场占有率60%,公司通过“低温锁定新鲜”、“自带智能清洁系统,每2小时或每40杯自动清洗”。“橙汁先生”品牌总经理表示“工作人员每天都会佩戴口罩、手套用纯净水进行清洁,收纳空间用臭氧消毒”。

